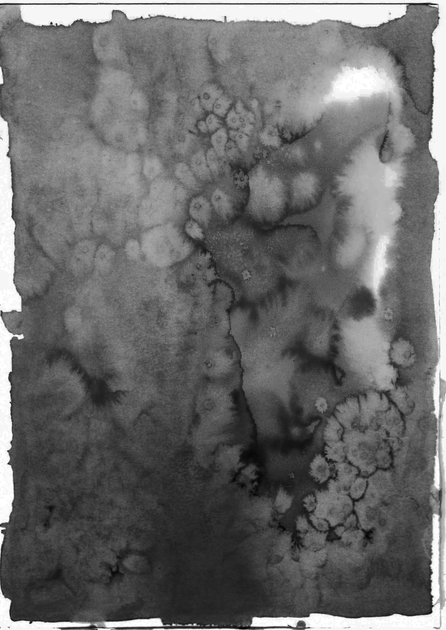

HOME | DD
Published: 2014-03-14 20:01:55 +0000 UTC; Views: 622; Favourites: 11; Downloads: 11
Redirect to original
Description
Dirty and bloody?Feel free to use it, but if you do, credit me and send me a link with your work, I'd love to see what you've done with it
And maybe donate a few points?